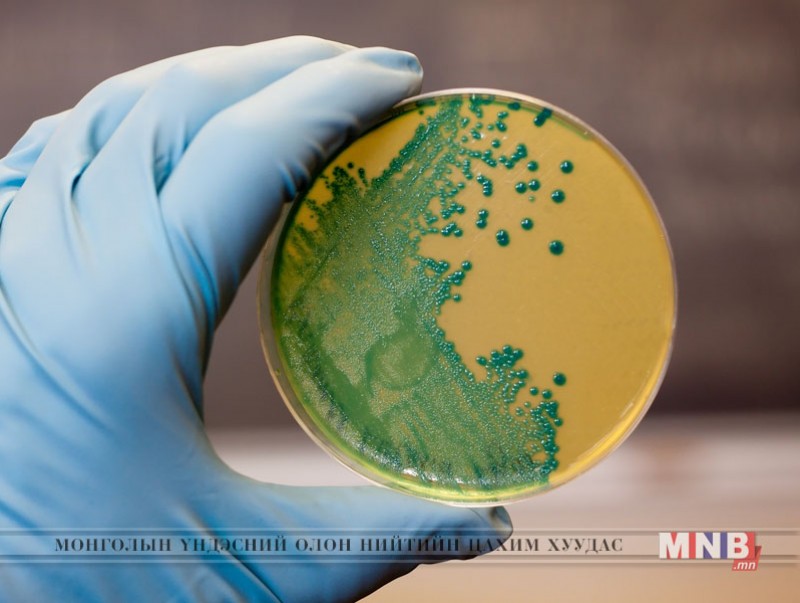

Сансар огторгуй дэлхийгээс дэндүү алс орших үлэмж том жинтэй объектүүдийг нууцалж байдаг тул маш том хүчирхэг дуран авиа хэрэглэх юмуу дэлхийн бүслүүр дээр тэдгээрийг байрлуулан ажиглалт хийснээр олж харах боломжтой мэт. Биднээс хэдэн мянган гэрлийн жилийн зайд орших од эрхэс, гаригуудын зураг, бичлэгийг одон орончид нэвт судлан, дүн шинжилгээ гаргадаг.
Тэгвэл бидний аж төрж буй энэ гариг дээр, бүр бидний хамар дор учир оньсого мэт нууцлагдмал амьдрал өрнөсөөр буйг бид анзаарах нь бүү хэл бараг л мэддэггүй. Тэр гайхамшигт амьдралыг тольдоход өртөг ихтэй, хүчирхэг техник ч шаардагдахгүй. Орчин үед бичил биетийн зургийг цахилгаан томруулагч дурангийн тусламжтайгаар 20-3500 дахин ихэсгэж авах боломжтой болсон.

Ийм хэтрүүлгийн ачаар нүднээ үл үзэгдэгч бичил биес 50 дахин томорч цочиж, сүрдмээр ер бусын төрхөө ил болгодог байна. Түүнээс гадна цахилгаан дуран авай нь эсийн бүтэц, байдлыг 500, 1000 бүр сая дахин томруулсан дүрслэлийг хамгийн орчин үеийн төхөөрөмжүүдэд буулгах чадвартай. Бичил биетийн бичлэг нь эрдэмтдэд тусгай төмөр, шилний гадаргуу юмуу хумхийн тоосыг судлахад тус болох юм.
Бичил амьд биесийг ч ялгаагүй. Нууцлагдмал амьдралтай бичил биесүүдийн амьдралыг тод дэлгэсэн сонирхолтой зургууд, тайлбараас бүтсэн гайхалтай номыг Их Британийн эрдэмтэн Брэндон Бролл хэвлүүлсэн байна. Түүний сонирхлыг хүний бие, амьтан, ургамал, ахуй гэсэн бичил сансрын хэдэн сэдэв татсан ажээ.

| Yл үзэгдэгч амьдралаас... | ||
| Үзсэн: 2755 | Mongolian National Broadcaster |


 Үндэсний телевиз
Үндэсний телевиз









































































































 Лханаагийн Мөнхтөр
Лханаагийн Мөнхтөр

 Р.Слава
Р.Слава

 Б.Цоожчулуунцэцэг
Б.Цоожчулуунцэцэг





Сэтгэгдэл бичих:
АНХААРУУЛГА: Уншигчдын бичсэн сэтгэгдэлд MNB.mn хариуцлага хүлээхгүй болно. ТА сэтгэгдэл бичихдээ хууль зүйн болон ёс суртахууны хэм хэмжээг хүндэтгэнэ үү. Хэм хэмжээг зөрчсөн сэтгэгдэлийг админ устгах эрхтэй. Сэтгэгдэлтэй холбоотой санал гомдолыг 70127055 утсаар хүлээн авна.